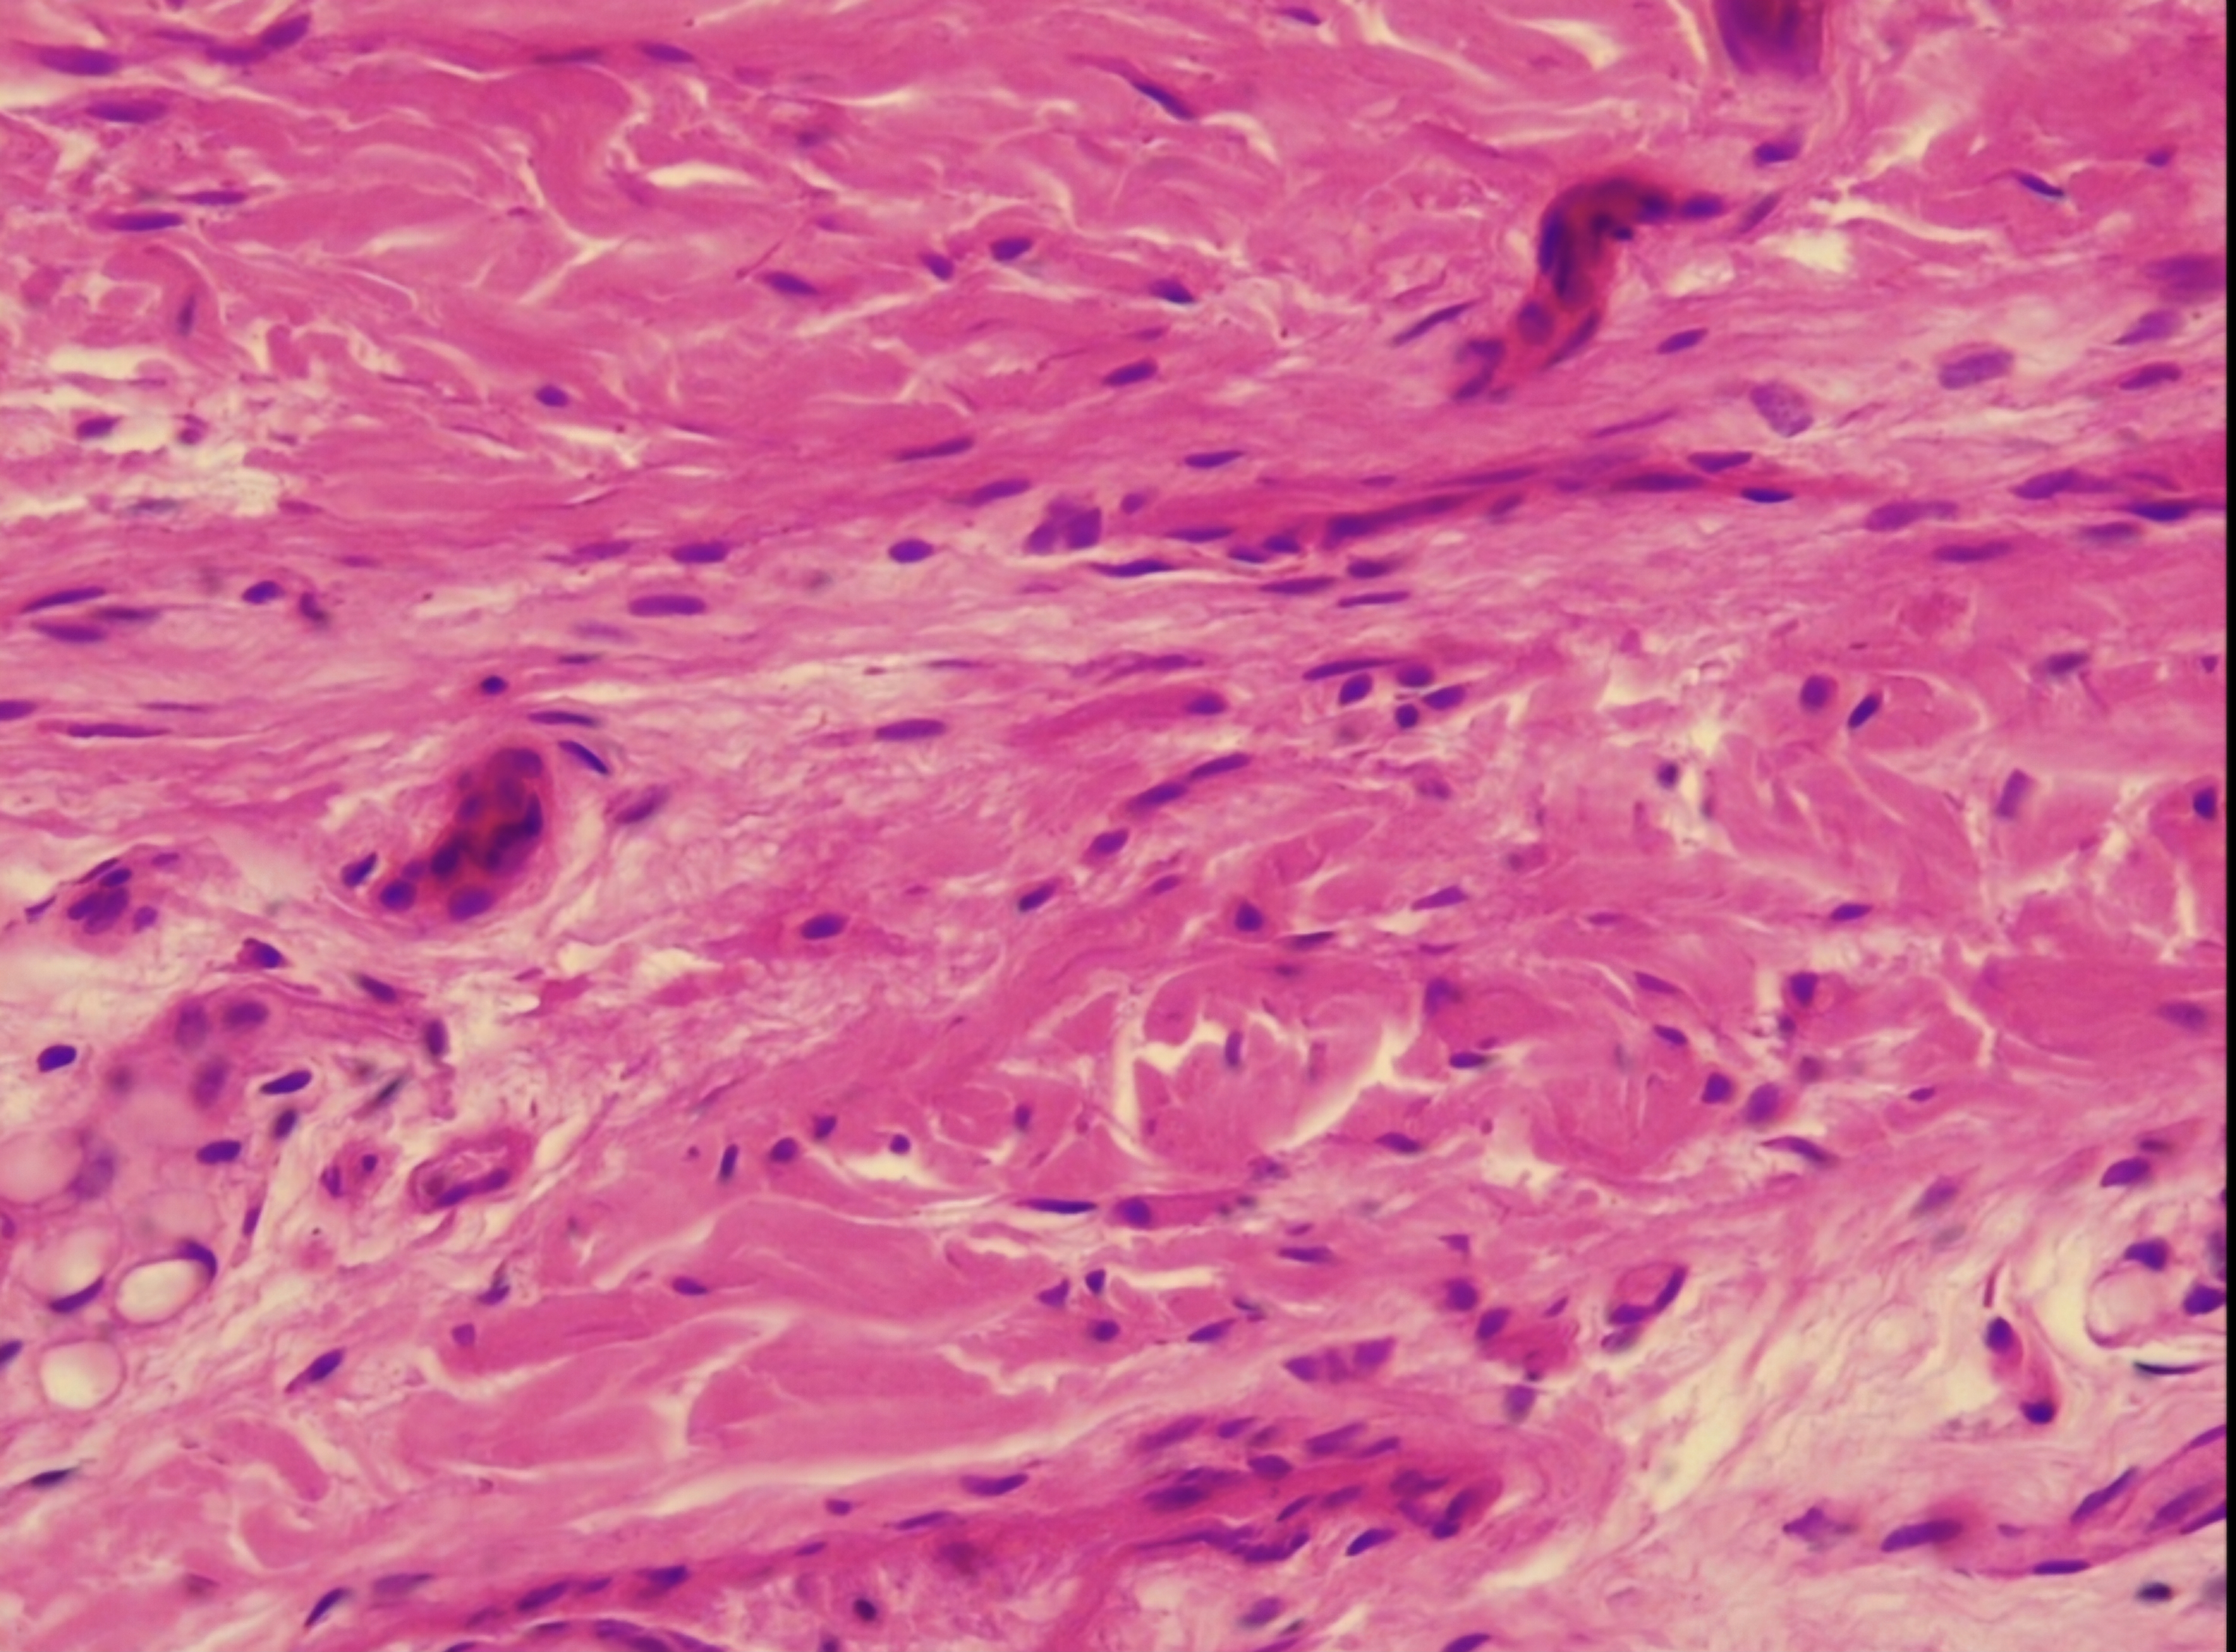
<p>Dense Irregular </p>
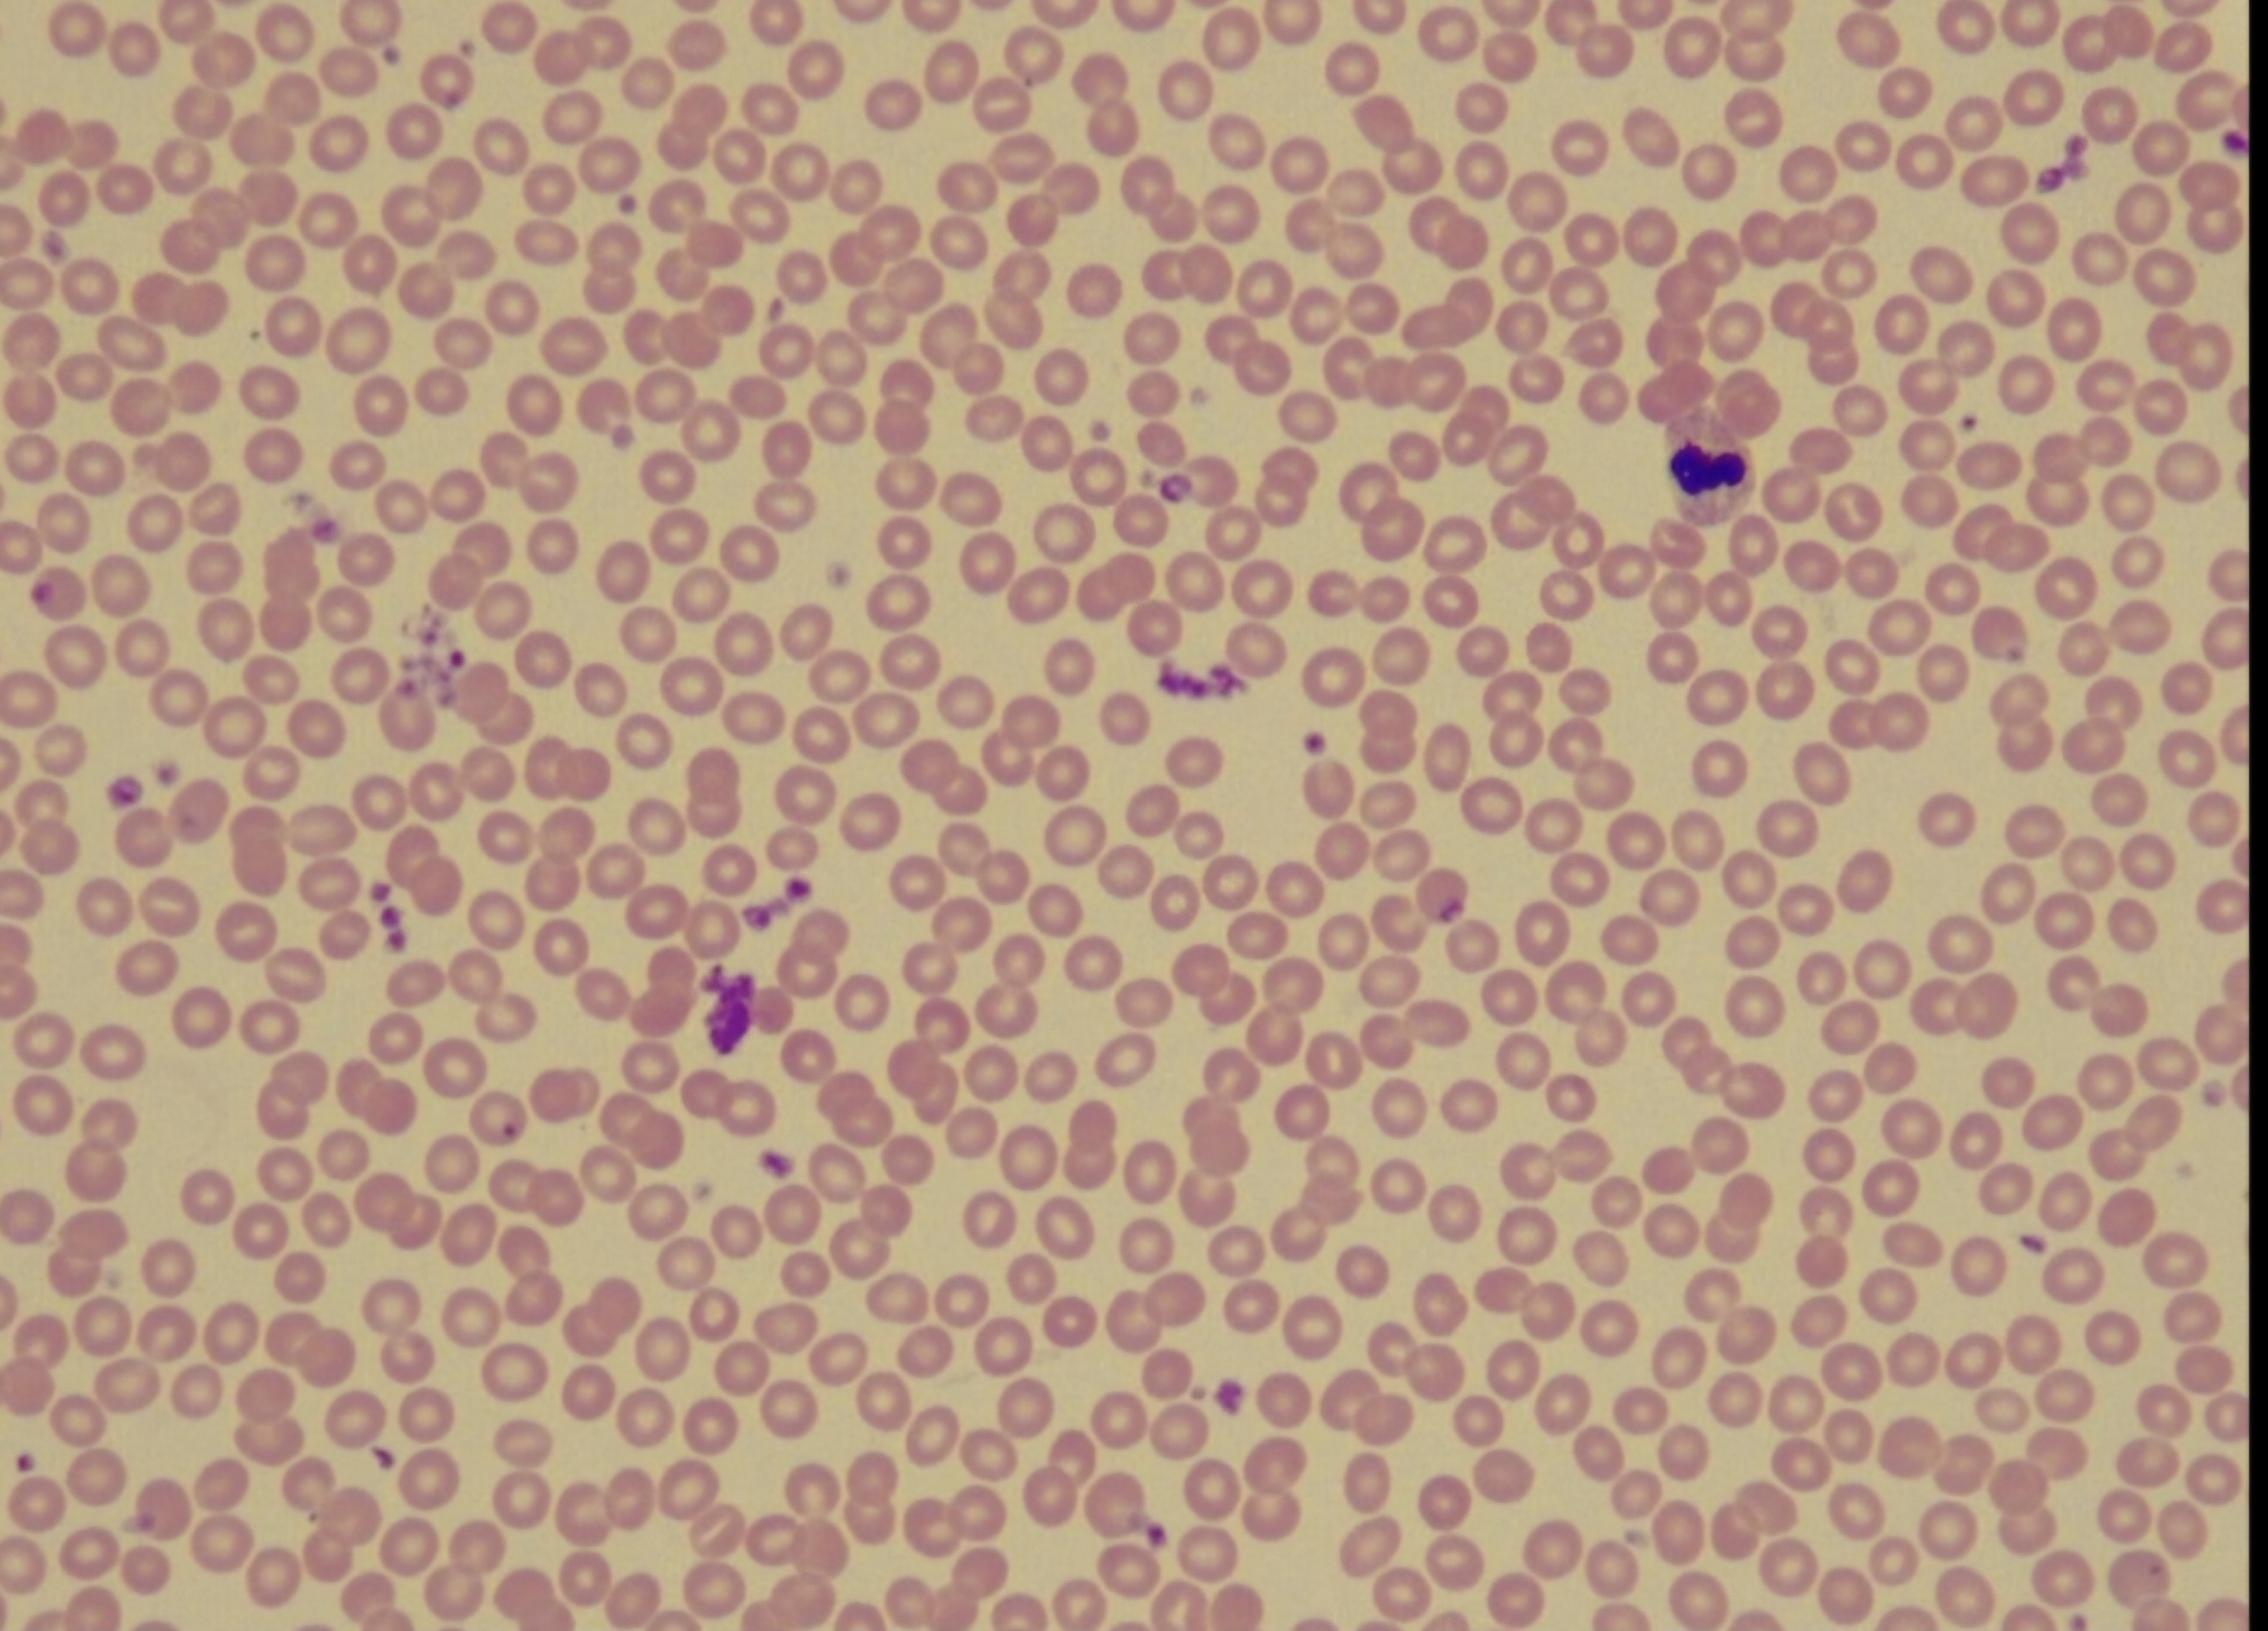
<p>Fluid ct (blood)</p>

1/11
Looks like no tags are added yet.
Name | Mastery | Learn | Test | Matching | Spaced | Call with Kai |
|---|
No analytics yet
Send a link to your students to track their progress
The extracellular Matrix
Ground substance foundation
Fiber: collagen (strong),elastic, reticular

Areolar
Cell:fibroblast
ECM: all 3 fiber
Function: “all purpose”
Location:all over the body

Adipose
Cell:adipocytes
ECM: all 3 fiber
Function: protection,insulator, alternative method to make ATP
Location:all over the body

Reticular
Cell: recticular
ECM: reticular
Function: inter skeleton
Location: lymphoid system

Dense regular
Cell:fiboblast
ECM: collagen
Function: connect bones,resisting and stretching in one direction
Location: tendon/ligament
Dense Irregular
Cell:fiboblast
ECM: collagen
Function: apply strength in many different directions
Location:skin

Dense elastic
Cell:fibroblast
ECM: collagen/elastic
Function: maintenance structure of oregons “rubber band”
Location:spine (other location too)

Hyaline carlige
Cell:chondrocyte
ECM: collagen
Function: smooth service for bone,support and maintain shape, act as a cushion,form the fetal skeleton
Location:between bones

Elastic cartilage
Cell:chondrocytes
ECM: collagen/elastic
Function: soild/bendable structure
Location:outer ear

Fibrocartilage
Cell:chondocytes
ECM: collagen
Function: provide strong support/with heavy support
Location:between bone of the spine

Bone
Cell:osteocytes
ECM: collagen/calcium
Function:support, protection,movement, mineral storage, blood cell protection,fat storage
Location:bone
Fluid ct (blood)
Cell:RBC/WBC
ECM: h20 (plasma)
Function: nutrients,oxygen and waste to be transported
Location:throughout the entire body